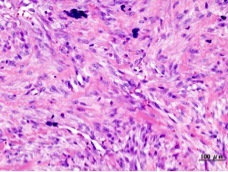
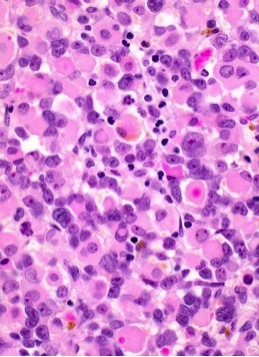

A 7yr old presented with a large swelling that has been progressively increasing for the past 3 yrs. Biopsy shows below. What’s the Dx?

Lipoma
A healthy, 53-year-old man presented with a small, soft, nontender mass of his right upper arm that progressively grew larger and firmer during the 6 weeks before evaluation. Micrograph show below. Dx?

Liposarcoma. Pic shows a lipoblast: very atypical cell with a bizarre nucleus and with vesicles of lipid in the cytoplasm
A 20 yr old comes in with history of a rapidly growing mass on the forearm. The mass is located in the subdermal fat and the biopsy is shown below. Dx?
Reactive Proliferans: Nodular Fasciitis
Histology depicts loose tissue cluture appearance
Male comes into the ER after suffering blunt trauma to his leg during a sporting event. The biopsy depicts woven bone that is well-formed at the periphery but immature bone is at the center . Xray below. Dx?

Reactive Proliferans: Myositis Ossificans
50 yr old male comes in with bilateral dupuytren contractures of both hands. Dx?
Superficial fibromatosis
You have a pt with a large locally aggessive tumor. Surgical exploration showed an encapsulated mass arising in the mesentery. Biopsy shows bland spindle cell proliferation with no mitotic figures and no necrosis. Dx?
Deep Fibromatosis
40 yr old male comes in with pain in his tibia. You get a biopsy shown below that demonstates herringbone pattern. Dx?

Fibrosarcoma
You suspect a fibrosarcoma in an 8yr pt. Biopsy confirms your Dx. The tumor has already metatasized. Prognosis?

Unlike fibrosarcoma in adults, the infantile form has an excellent prognosis, even in the face of metastatic disease at presentation, when treated with a combination of chemotherapy and resection.
You find a firm brown nodule on your pt’s arm. She said she previously had an insect bite in that location. If the skin over the nodule were squeezed it would form a dimple. Biopsy shown below. Dx?

Dermatofibroma aka fibrous histiocytoma.
What is this?

Dermatofibrosarcoma protuberans
You discover a tumor in your pt which histologically shows typical spindle cells arranged in a “storiform” pattern. There are also bizarre giant cels shown below. Dx?

Malignant fibrous histiocytoma
This tumor has a white fish flesh appearance grossly. Histology shows elongated strap cells (shown below) and are bizarre cells with abundant pink cytoplasm. Dx?

Rhabdomyosarcoma.
These are the bizarre cells with abundant pink cytoplasm
You discover a large tumor on the uterus of you pt. Biopsy shown. Dx?

Leiomyoma
You get a biopsy of a suspected leiomyoma. What does this biopsy tell you about the prognosis?

The biopsy shows typical cigar shaped nuclei which could be seen in leiomyoma or in leiomyosarcoma, but the in the middle of the image there are 2 mitotic figures within one field, a very worrisome observation. This would be typical of a lower grade leiomyosarcoma. Worse prognosis than leiomyoma